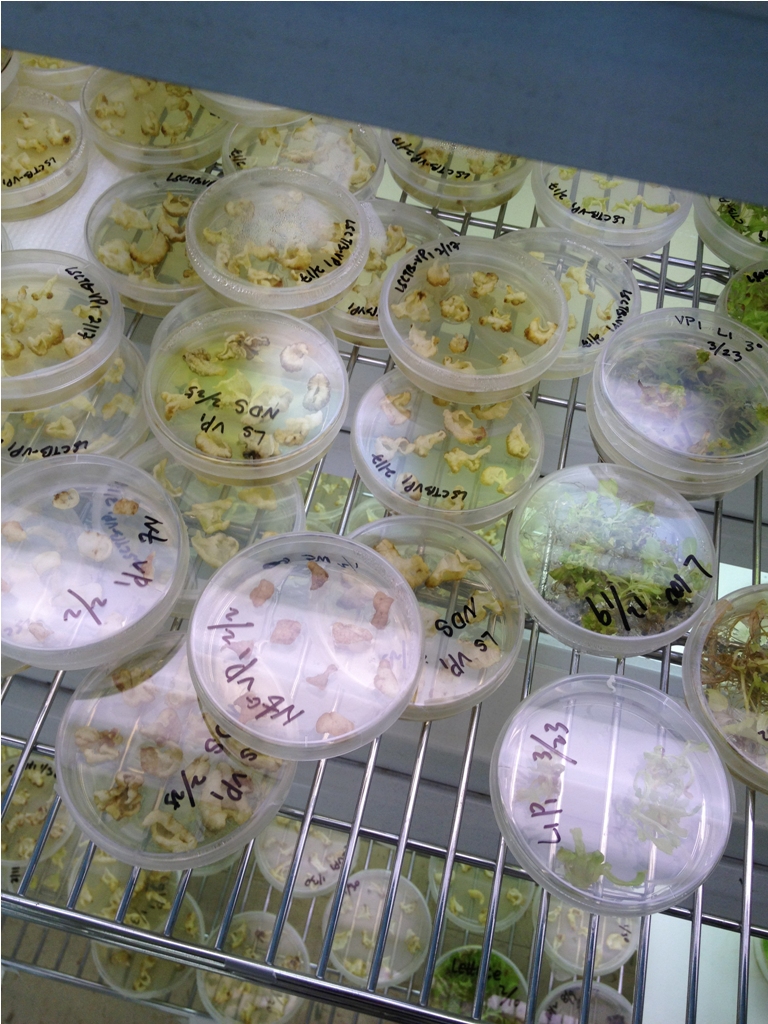

No dia 3 de abril, às 23h15, estreia a nova série do National Geographic Channel, O Início Do Fim. Em seis episódios, dramatizações, computação gráfica e grandes especialistas explicam como sairíamos da Terra quando o apocalipse chegar.
Todas as quintas-feiras, o fim do mundo é explorado pelo programa. No primeiro episódio,"Apocalipse Zumbi", o cenário mais real possível de uma pandemia criada por uma mutação do vírus da raiva é criado. Especialistas das áreas de medicina, biologia e ciências sociais explicam o que poderia acontecer se a humanidade enfrentasse uma epidemia mortal para a qual não há nenhuma cura.
Confira

Por Luísa Venter
Atualizado em 2 Abr 2014.